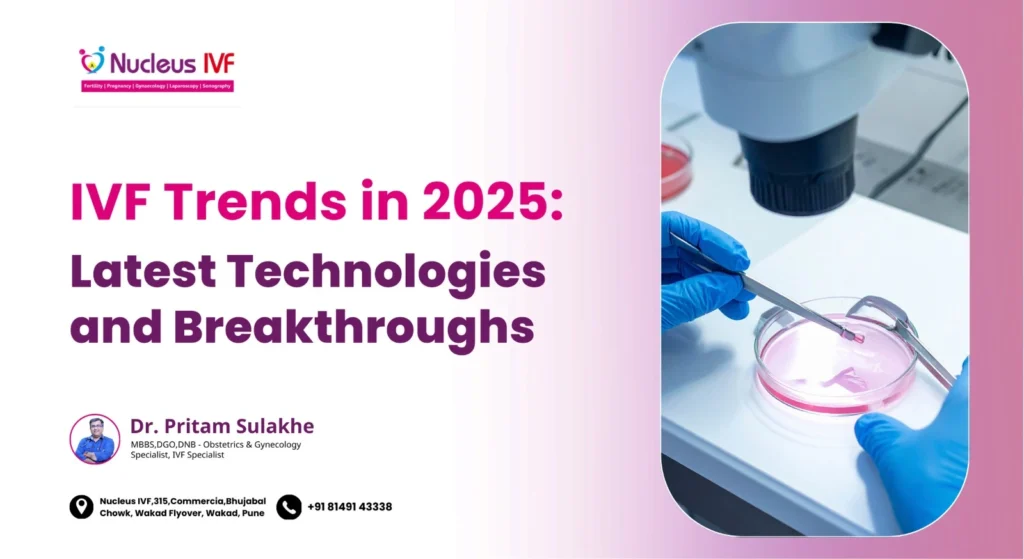
IVF Trends in 2025_ Latest Technologies & Breakthroughs _ Dr. Pritam Sulakhe

Top 10 Questions to Ask Your Fertility Specialist Before Starting IVF

Planning IVF? Dr. Pritam Prakash Sulakhe at Nucleus IVF, Pune shares the most important questions to ask before starting IVF. Book your consultation today.
Difference Between IVF, ICSI, IUI and Other Fertility Treatments

Confused between IVF, ICSI, and IUI? Dr. Pritam Prakash Sulakhe at Nucleus IVF, Pune explains the differences. Book a fertility consultation today.
Preparing Body & Mind Before IVF | Dr. Pritam Prakash Sulakhe

Get IVF-ready with expert guidance from Dr. Pritam Prakash Sulakhe at Nucleus IVF, Pune. Learn nutrition, stress, and lifestyle tips. Book a consultation today.
IVF Success Rates: What Affects Them & Realistic Expectations

Discover the latest IVF trends in 2025, including advanced technologies and breakthroughs improving success rates. Expert insights by Dr. Pritam Sulakhe, IVF Specialist in Pune.
IVF Treatment in India: A Clear Step-by-Step Guide for Beginners

Discover the latest IVF trends in 2025, including advanced technologies and breakthroughs improving success rates. Expert insights by Dr. Pritam Sulakhe, IVF Specialist in Pune.
IVF Trends in 2025: Latest Technologies & Breakthroughs | Dr. Pritam Sulakhe
Discover the latest IVF trends in 2025, including advanced technologies and breakthroughs improving success rates. Expert insights by Dr. Pritam Sulakhe, IVF Specialist in Pune.
Fertility Preservation – Egg & Sperm Freezing Guide

Dr. Pritam Prakash Sulakhe, IVF Specialist at Nucleus IVF, Pune, explains that fertility preservation has become an empowering option for individuals and couples who wish to plan parenthood on their own timeline. With advancements in reproductive medicine, egg and sperm freezing now offer safe, reliable, and effective ways to protect fertility for the future What […]
Rising Infertility in Younger Couples: Causes & Solutions | Dr. Pritam Sulakhe

Infertility is increasing among younger couples due to lifestyle and medical factors. Learn the causes and effective solutions explained by Dr. Pritam Sulakhe, IVF Specialist in Pune.
Mild Stimulation IVF vs Conventional IVF:

Understand the key differences between Mild Stimulation IVF and Conventional IVF. Dr. Pritam Prakash Sulakhe explains which approach is best based on age, fertility health, and treatment goals.
How AI Improves your IVF Cycle?

explore how AI-driven embryo selection enhances IVF success with precise, data-backed embryo grading. Learn how advanced tech supports better outcomes at Nucleus IVF. Call us now!